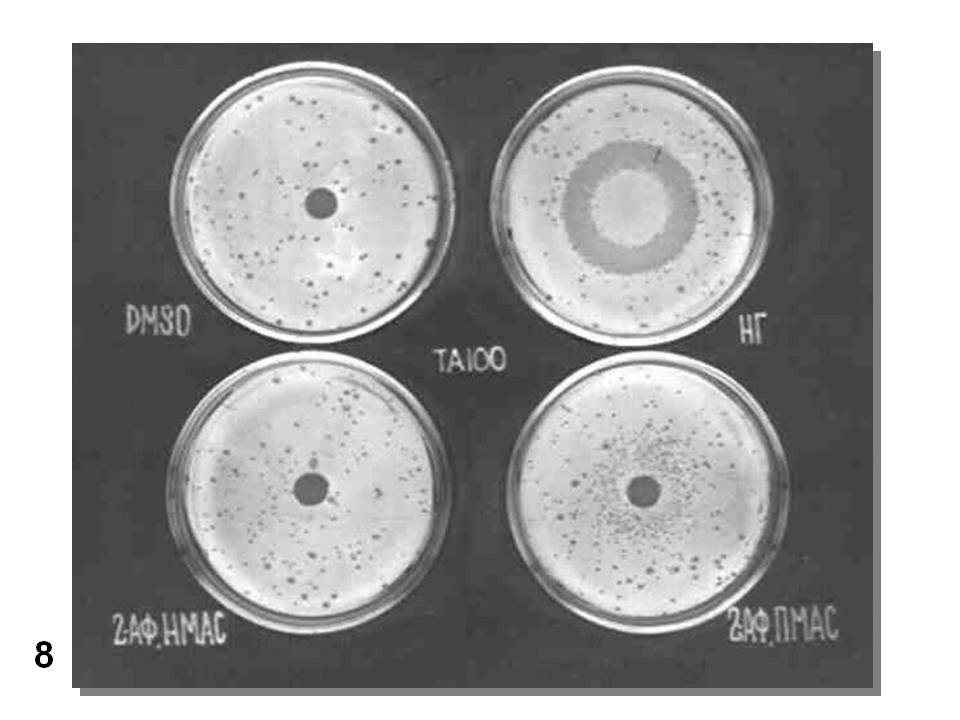

Вы здесь
Главная › Научные советы › Экология и природные ресурсы › Научно-образовательный проект "Наука-школе" ›Генетическая токсикология. Что это такое?
Год «экологии» (Человек как фактор эволюции)
Мы вступили в «Год экологии и природных охраняемых территорий» в нашей стране. Это подразумевает повышенное внимание к состоянию окружающей природы, ее обитателей и той среды, в которой они живут, и живем мы с вами. Последнее заслуживает особого внимания. Человек, в отличие от других живых существ, в особенности животных, не столько выбирает для себя среду обитания, сколько изменяет ее для собственных потребностей. И, чем дальше, тем больше! Оглянитесь и вы увидите города и поселки, дороги, водные и воздушные пути сообщения, заводы, фабрики и сельско-хозяйственные предприятия, засоряющие нашу среду обитания, вспомните медицину, производящую все новые биологически-активные вещества. Человек, являясь продуктом биологической эволюции, сегодня сам стал фактором этой эволюции на Земле. Вспомните примеры преднамеренного и не преднамеренного переселения животных и растений в новые для них районы и условия обитания. Хорошо известный пример – борщевик Сосновского, не осмотрительно акклиматизированный в наших широтах. Для корма он не пригодился. Ядовит! Зато расплодился повсеместно. Как бороться с ним, не знаем. Образ современности символизирует комнатная, а то и навозная муха, пресекающая Атлантику в салоне Боинга. А в мухе что? Стоит задуматься! А что делает китайский краб в Балтийском море и как он туда попал?
Эту тему можно развивать дальше, но сегодня мы поговорим о другом. Поговорим о загрязнении окружающей среды физическими факторами – различными типами излучений и химическими соединениями, производимыми для сельского хозяйства, медицины, присутствующими в выхлопных газах автомобилей и производственных выбросах. Мало того, что они часто ядовиты. Этой проблемой занимается общая токсикология. Они еще и действуют на генетический материал микроорганизмов, растений животных и человека, влияя на их наследственную изменчивость. А этой проблемой занимается генетическая токсикология.
Классификация изменчивости, эволюция, генетический груз
Как мы уже отметили человек – продукт биологической эволюции, в основе которой лежат изменчивость и дарвиновский естественный отбор. Какие типы изменчивости нам известны? Их классификация – на картинке (Рис. 1). Нас, прежде всего будет интересовать наследственная изменчивость: мутационная и комбинативная. В последнем случае нас будет интересовать кроссинговер, или реципрокный обмен участками хромосом. Вспомним курс школьной биологии. Эта классификация несколько условна, поскольку в основе некоторых «мутаций» лежит механизм рекомбинаций, в частности, в основе транспозиций и хромосомных перестроек.

Рис. 1. Классификация типов изменчивости (Инге-Вечтомов, 2015).
Именно наследственная изменчивость, прежде всего, мутационная, лежит в основе эволюции, поставляя материал для естественного отбора. И вот тут у человека опять все не как у всех. Естественный отбор уже не играет той роли в быстром прогрессе вида Homo sapiens, какую он играет в остальной живой природе. Вспомните сколько миллионов лет прошли прежде, чем позвоночные, вышедшие на сушу, обрели крылья и полетели. В то же время человек вышел в космос в течение одного-двух поколений, не приобретя никаких морфологических изменений. Эволюция человека перешла в область культуры.
Полезные мутации редки. Большинство мутаций вредны и их отметает естественный отбор. У человека, благодаря успехам медицины целый ряд наследственных аномалий не приводит к летальному исходу. Вспомним такие наследственные аномалии метаболизма, как фенилкетонурия, галактоземия и многие другие. Таких больных спасает специальная диета. Вспомним гемофилию, дальтонизм. А синдром Дауна (лишняя 21-я хромосома) и пр. и пр. И это только вершина айсберга – только часть генетического груза, который человечество хранит и в гетерозиготном состоянии. Только моногенные (менделирующие) заболевания проявляют 2,5% населения земного шара (Горбунова, Корженевская – ред., 2015). Это – более 12,5 миллионов человек. Общий объем генетического груза, включающий также полигенные и хромосомные аномалии, в Европе и России составляет около 5,5% (Баранов – ред., гл. 2, 2009).
Мутационный процесс как ящик Пандоры
До 1925 г. было общепринято, что мутации происходят только спонтанно. Мутагенез, индуцированный рентгеновыми лучами у низших грибов, открыли наши соотечественники (Надсон, Филиппов, 1925). Вскоре аналогичный эффект описал у плодовой мушки-дрозофилы американец Г.Дж.Мёллер (Müller, 1927), а М.Н.Мейсель, работавший в лаборатории Г.А.Надсона, вскоре открыл химический мутагенез у дрожжей (Мейсель, 1928). С тех пор число физических и химических внешних факторов, вызывающих мутации, росло очень быстро, особенно после доказательства в 40-е – 50-е гг ХХ в генетической роли ДНК и расшифровки ее структуры (Рис. 2) Дж.Уотсоном и Ф.Криком (см. Инге-Вечтомов, 2015). Стало очевидным, что частоту мутаций (и рекомбинации – кроссинговера) вызывают агенты, прямо или косвенно влияющие на структуру ДНК. Классификация мутаций, принятая в настоящее время, представлена на (Рис. 3).

Рис. 2. Структура дезоксирибонуклеиновой кислоты (ДНК).

Рис. 3. Типы мутаций (Абилев, Глазер, 2015).
Открытие индуцированного мутагенеза можно сравнить с открытием ящика Пандоры. Очень скоро стало очевидным, что для каждого нового химического соединения, используемого человеком в медицине (лекарства), сельском хозяйстве (инсектициды, пестициды, удобрения), в качестве пищевых добавок, не говоря уже о выбросах промышленности и транспорта, необходимо доказывать, что оно не обладает мутагенной, рекомбиногенной активностью. Говоря иначе, нужно доказывать, что вещество не обладает генетической активностью. Один из вариантов классификации химических мутагенов (Абилев, Глазер, 2015) представлен на следующей иллюстрации (Рис. 4).

Рис. 4. Типы химических мутагенов (Абилев, Глазер, 2015).
Учитывая сказанное ранее, очевидно, что появление новых, генетически активных соединений в окружающей среде грозит увеличением генетического груза человечества со всеми вытекающими последствиями для здоровья человека. Задачу выявления генетической активности внешних факторов и предотвращения или ограничения их использования (при наличии таковой) решает прикладной раздел генетики – генетическая токсикология. Здесь уместно отметить, что существует высокая степень корреляции (до 90%) между мутагенной и канцерогенной активностью различных агентов. Таким образом, генетическая токсикология заботится как о здоровье будущих поколений человечества, так и о здоровье ныне живущих людей.
Генетическая токсикология
Генетическая токсикология опирается на фундаментальные исследования механизмов мутационного процесса, как для обнаружения генетической активности, так и для предотвращения ее проявления. При этом необходимо учитывать следующие положения (Рис. 5):
- Некоторые агенты (химические соединения) являются реальными мутагенами, а некоторые – потенциальными, или промутагенами. Последние требуют для превращения в мутагены активации некоторыми ферментативными системами организма, в частности цитохромами группы P450, содержащимися в микросомной фракции клеток печени и обычно отвечающими за детоксификацию ксенобиотиков.
- Взаимодействие химического (как и физического) генетически активного агента с ДНК сопровождается ее повреждением: однонитевыми или двунитевыми разрывами, окислением, алкилированием, димеризацией и другими химическими модификациями нуклеотидов ДНК. Это еще не мутации. Это первичные, или предмутационные повреждения ДНК. В клетке существует множество ферментов репарации, которые обнаруживают эти повреждения и устраняют их, исправляя (репарируя) структуру ДНК. При этом исправлена должна быть общая химическая структура ДНК, и не обязательно ее исходная нуклеотидная последовательность. Таким образом в результате т. н. ошибок репарации первичные повреждения превращаются в мутации. Впервые понятия «мутация» и «репарация» поставил рядом М.Е.Лобашёв в 1946 г (Лобашёв, 1946, 1947). При этом нужно учитывать, что репарация ДНК касается не мутаций, а первичных, или предмутационных повреждений.
- Наконец, уже возникшая мутация, даже рецессивная, может сразу же проявиться, например, у гаплоидного организма, но может не проявиться у диплоида, если она рецессивна или, даже у гаплоида в следствие генных взаимодействий (эпистаза, супрессии).

Рис.5. Пути превращения химических мутагенов и проявления мутаций.
Вмешаться в возникновение и проявление мутации можно на всех упомянутых этапах. Ситуацию осложняет невозможность ставить опыты на человеке, хотя нас интересуют, в первую очередь, как будут влиять генетически активные факторы , прежде всего, на человека, хотя и не только. Обойти это осложнение в значительной степени позволяет использование модельных объектов с учетом биологической квази-универсальности исследуемых процессов. При этом всегда остается вопрос, в какой мере результаты, полученные на модельных объектах, или тест-системах можно переносить на человека. Существенными требованиями к тест-системам является также простота их использования и малые затраты времени.
В настоящее время существует большое число тест-систем (десятки), использующих различные объекты и учитывающие различные генетические эффекты. Лишь небольшое число из них приняты как стандартные в международной практике и утвержденные в нашей стране. Я приведу минимальный перечень из 8-и тест-систем (Рис. 6) и остановлюсь более подробно на некоторых из них.

Рис. 6. Минимальный набор тестов, рекомендованных для генетической токсикологии.
Наиболее популярной можно считать тест-систему Б.Эймза с использованием мутантов Salmonella typhimurium, нуждающихся в гистидине. Это отличный пример того, как поначалу чисто теоретическое исследование структуры и функций гистидинового оперона бактерии-сальмонеллы (Ames et al, 1960) нашло практическое применение в виде тест-системы для идентификации мутагенов, вызывающих вставки-выпадения и замены нуклеотидов в ДНК, благо авторы этих исследований получили большую коллекцию таких мутантов, подробно охарактеризованных на молекулярном уровне. Тогда мутант His- , возникший в следствие вставки (выпадения) лишней пары нуклеотидов, будет ревертировать His- → His+ , т. е. восстанавливать прототрофность по гистидину, под действием мутагенов, вызывающих выпадения (вставки) пары нуклеотидов. Аналогично, мутанты, возникшие в результате замены пары нуклеотидов, будут ревертировать под действием мутагенов, вызывающих замены пар нуклеотидов.
Подкупает простота применения системы Эймза, особенно в варианте т. н. спот-теста. Достаточно засеять чашки Петри со средой без гистидина мутантом His- и поместить в центр чашки кружок фильтровальной бумаги, пропитанный испытуемым веществом или каплю этого вещества. Уже через сутки в этом качественном тесте можно видеть скопление мутантов (ревертантов) вокруг пятна испытуемого вещества, если оно мутагенно. Контролем служат такие же чашки с нанесением дистиллированной воды или только растворителя, не содержащего испытуемого вещества (Рис. 7).

Рис. 7. Варианты спот-теста (схема) для проверки мутагенности химического соединения.
Реально эксперимент ставят несколько сложнее. Генетическая токсикология – редкий пример в биологии, когда ставят не только негативный контроль - без воздействия, но и позитивный контроль – с воздействием заведомо активного мутагена, а также при активации промутагена экстрактом микросомной фракции печени мыши или крысы, как это показано на (Рис. 8). На этой картинке показаны результаты испытания мутагенной активности 2-аминофлуорена при действии на мутант His- TA100 S. typhimurium, возникший в результате замены пары оснований в одном из генов гистидинового оперона.

Рис. 8. Проверка мутагенной активности 2-аминофлуорена (2АФ) (по: Инге-Вечтомов, 2015).
Варианты эксперимента:
DMSO – диметилсульфоксид, растворитель без мутагена – негативный контроль;
НГ – нитрозогуанидин, заведомо мутагенное соединение – позитивный контроль;
2АФ, НМАС – 2-аминофлуорен в неполной мутагенной активирующей смеси, т.е. без активирующей микросомной фракции печени (НМАС);
2АФ, ПМАС – 2-аминофлуорен в полной мутагенной активирующей смеси, т. е. с добавлением активирующей микросомной фракции.
Сравнение вариантов опыта показывает, что 2-аминофлуорен – про-мутаген (сам по себе не мутагенен), активируемый при добавлении ферментов микросомной фракции печени (вариант 2АФ, ПМАС).
Другая популярная тест-система – учет рецессивных сцепленных с полом (в Х-хромосоме) летальных мутаций у Drosophila melanogaster (Рис. 9), которая восходит к самой первой системе Г.Дж.Мёллера, для учета мутаций, индуцированных рентгеновыми лучами (Müller, 1927). Для этой системы характерна некоторая неоднозначность, касающаяся исследуемых признаков (жизнеспособность) и генетических изменений. Как показали более поздние исследования, большинство летальных мутаций в Х-хромосоме представляют собой небольшие хромосомные перестройки – делеции. Испытуемое соединение подмешивают в корм для мух. Этот тест требует около 20 дней, в течение которых проходят два поколения дрозофилы, а учет проводят во втором поколении (Рис. 10). Напомню, что Y-хромосома (обозначена крючком) D. melanogaster генетически инертна (почти не содержит генов), поэтому в ее присутствии (у самцов) проявляются рецессивные мутации в Х-хромосоме. «Опыт» обозначает Х-хромосому, в которой учитывают летальные мутации. В норме (в контрольном варианте), - без леталей в этой хромосоме (вариант а) в F2 самцов в два раза меньше, чем самок. Половина самцов гибнет, получая исходно летальную хромосому CLB. В индивидуальных скрещиваниях самцов, подвергшихся мутагенному воздействию и получивших рецессивную летальную мутацию в хромосоме «опыт» (вариант б) самцов не будет вообще. Частота таких бессамцовых культур и характеризует генетическую активность испытываемого соединения.

Рис. 9. Жизненный цикл Drosophila melanogaster (cлева). Справа – самка (вверху) и самец (внизу) D. melanogaster.

Рис. 10. Схема скрещиваний (метод CLB) для выявления рецессивных летальных мутаций в Х-хромосоме D. melanogaster.
Можно учитывать хромосомные аберрации в различных клетках млекопитающих (чаще всего мышей) и других организмов (как животных, так и растений). Пример см. на (Рис. 11А). Более того, можно учитывать последствия действия потенциальных мутагенов непосредственно на ДНК, которую экстрагируют после применяемого воздействия и подвергают электрофорезу. При этом учитывают появление низкомолекулярной фракции ДНК, как следствие ее разрывов при воздействии на подопытный организм (Рис. 11Б). Естественно для сравнения исследуют варианты негативного и позитивного контроля. Попутно отметим, что на рис. 11 представлены последствия мутагенного эффекта стресса у мышей (Даев, Дукельская, 2014). Аналогичным образом можно исследовать и другие объекты, например, рачка бокоплава (рис. 12) (Даев и др., 2014).

Рис. 11. Примеры нарушений генетического материала в результате феромонального стресса у мышей: Рис. 11А – хромосомные аберрации. Рис 11 Б – примеры разрушения ДНК, выявляемые в электрофорезе (кометный тест) (Даев, Дукельская, 2014).

Рис. 12. Хромосомные перестройки в митозе у бокоплава (Gmelinoides fasciatus). (Даев и др., 2014).
Наконец, зная, что большинство повреждений генетического материала индуцирует его последующую репарацию, в некоторых тестах учитывают активность ферментов репарации. Тогда повышение их активности отражает степень повреждения ДНК.
Мы не можем рассмотреть весь набор тест-систем, даже рекомендованных госфарм-комитетом. Для этого потребовалось бы много времени и знания частной генетики используемых объектов. Тем не менее, приведенные примеры показывают, что каждый тест специализирован для учета конкретного типа генетических эффектов: точковые мутации, хромосомные перестройки, митотическая рекомбинация, рецессивные и доминантные летали, фрагментация ДНК и т. д. Кроме того, всегда остается вопрос о возможности экстраполяции наблюдаемого эффекта на человека. Даже изучение хромосомных аберраций в соматических клетках человека не гарантирует, что наблюдаемые эффекты можно переносить на половые клетки человека. Поэтому наряду с применением различных тест-систем необходимо применение системы тестов, как это показано, например на (Рис. 13) (Бочков и др., 1984). Окончательное решение об использовании, например, того или иного лекарства следует принимать, учитывая совокупность эффектов на разных тест-системах.

Рис. 13. Схема последовательных этапов тестирования лекарственных препаратов на мутагенную активность (Бочков и др., 1984).
Таким образом, предпочтение следует отдавать тест-системам, вскрывающим максимальное число генетических эффектов, тест-системам приближенным в систематическом плане к человеку и не слишком трудоемким, учитывая, что от системы тестов нам никуда не уйти. Еще одно важное дополнение. Теперь хорошо известно, что любому учитываемому генетическому эффекту, которые мы перечисляли ранее, предшествует первичное повреждение генетического материала. Ни одна из рекомендованных тест-систем не позволяет учитывать фенотипическое проявление этих повреждений. Как мы убедились в своей работе, большую часть первичных повреждений, системы репарации устраняют бесследно (для генетического материала), но они успевают проявиться фенотипически (Степченкова, Инге-Вечтомов, 2011). Так могут возникать врожденные, хотя и не наследуемые аномалии.
Достаточно быстрое развитие генетической токсикологии позволяет постепенно решать эти проблемы. В то же время разработка каждой новой тест-системы и попытки включения ее в стандартный рекомендованный перечень требует пересмотра всей этой системы тестов для характеристики испытуемых веществ и других внешних факторов с тем, чтобы результаты разных исследователей были сопоставимы друг с другом.
В заключение следует напомнить, что генетически активные факторы окружающей среды действуют не на отдельные, изолированные организмы, а на экосистемы, в которых взаимодействуют организмы разных видов. Человек сам по себе представляет сложную экосистему: в его кишечнике, полости рта, на поверхности кожи и т. д. обитает множество микроорганизмов – бактерий, грибов, простейших (Рис. 14), в том числе и условно патогенных. Повышение мутабильности грозит превращением их в реально патогенные формы. Ситуацию осложняет и то обстоятельство, что подавляющее большинство видов микроорганизмов – наших эндосимбионтов вообще не охарактеризованы, поскольку их не удается культивировать на искусственных средах.

Рис. 14. Наша микрофлора (Финлей, 2010).
Это, по необходимости краткое, знакомство с генетической токсикологией показывает, сколь интеллектуально насыщенной является эта прикладная область биологии и как она зависит от успехов фундаментальной науки.
Литература
Абилев С.К., Глазер В.М. Мутагенез с основами генотоксикологии. М., СПб. Нестор-История. 2015. 304 с.
Баранов В.С. (ред) Генетический паспорт – основа индивидуальной и предиктивной медицины. СПб: Изд Н-Л, 2009. 528 с.
Бочков Н.П., Захаров А.Ф., Иванов В.И. Медицинская генетика. Руководство для врачей. М. Медицина 1984. 368 с.
Горбунова В.Н, Корженевская М.А. (ред.) Генетика в клинической практике. СПб: СпецЛит, 2015. 329 с.
Даев Е. В., Дукельская А. В. «Общественная нервная система» и стабильность генома каждого: моделирование на животных. В сб.: 9-я Всероссийская научно-практическая конференция с международным участием "Здоровье — основа человеческого потенциала: проблемы и пути их решения", 20-22 ноября (приглашенный доклад), СПб: Изд-во Политехнического университета, 2014, Т.9(1). С. 118-120.
Даев Е. В., Дукельская А. В., Барабанова Л. В. 2014. Цитогенетические методы индикации экологической напряженности в водных и наземных биосистемах // Экологическая генетика. Т. 12, № 2, c. 4-10.
Инге-Вечтомов С.Г. Генетика с основами селекции. СПб: Изд. Н-Л, 2015. 718 с.
Лобашёв М.Е. О природе действия внешних условий на динамику мутационного процесса. Тзисы дисс. На соискание ученой степени доктора биол. наук. Л, 1946. 3 с.
Лобашёв М.Е. Физиологическая (паранекротическая) гипотеза мутационного процесса. Вестник Ленингр. Университета. 1947. №8, с. 10-29.
Мейсель М.Н. Влияние хлороформа на развитие дрожжей. Микробиологич. журн. 1928. Т. 6, с. 225.
Надсон Г.А., Филиппов Г.С. Влияние рентгеновских лучей на половой процесс и образование мутантов у низших грибов (Mucoraceae). Вестник рентгенол. и радиол. 1925. №3, с. 305-310.
Степченкова Е.И., Инге-Вечтомов С.Г. Альфа-тест – система для учета первичных повреждений и их превращения в наследуемые изменения генетического материала. Жизнь без опасности. 2011. Т. VI. № 4. С.38-44.
Финлей Б. Боевые искусства бактерий. В мире науки. 2010. №4. С. 44-51.
Ames B.N., Garry B., Herzenberg L.A. The genetic control of the enzymes of histidine biosynthesis in Salmonella typhimurium. J Gen Microbiol. 1960 Apr;22:369–378.
Müller H.J. Artificial transmutation of the gene. Science. 1927. V.46, P. 84-87.
Список иллюстраций
Рис. 1. Классификация типов изменчивости (Инге-Вечтомов, 2015).

Рис. 2. Структура дезоксирибонуклеиновой кислоты (ДНК).

Рис. 3. Типы мутаций (Абилев, Глазер, 2015).

Рис. 4. Типы химических мутагенов (Абилев, Глазер, 2015).

Рис.5. Пути превращения химических мутагенов и проявления мутаций.

Рис. 6. Минимальный набор тестов, рекомендованных для генетической токсикологии.

Рис. 7. Варианты спот-теста (схема) для проверки мутагенности химического соединения.

Рис. 8. Проверка мутагенной активности 2-аминофлуорена (2АФ) (по: Инге-Вечтомов, 2015).
Варианты опыта:
DMSO – диметилсульфоксид, растворитель без мутагена – негативный контроль;
НГ – нитрозогуанидин, заведомо мутагенное соединение – позитивный контроль;
2АФ, НМАС – 2-аминофлуорен в неполной мутагенной активирующей смеси, т.е. без активирующей микросомной фракции печени (НМАС);
2АФ, ПМАС – 2-аминофлуорен в полной мутагенной активирующей смеси, т. е. с добавлением активирующей микросомной фракции.
Рис. 9. Жизненный цикл Drosophila melanogaster (cлева). Справа – самка (вверху) и самец (внизу) D. melanogaster.

Рис. 10. Схема скрещиваний (метод CLB) для выявления рецессивных летальных мутаций в Х-хромосоме D. melanogaster.

Рис. 11. Примеры нарушений генетического материала в результате феромонального стресса у мышей: Рис. 11А – хромосомные аберрации. Рис 11 Б – примеры разрушения ДНК, выявляемые в электрофорезе (кометный тест) (Даев, Дукельская, 2014).

Рис. 12. Хромосомные перестройки в митозе у бокоплава (Gmelinoides fasciatus). (Даев и др., 2014).

Рис. 13. Схема последовательных этапов тестирования лекарственных препаратов на мутагенную активность (Бочков и др., 1984).

Рис. 14. Наша микрофлора (Финлей, 2010).

- 11062 просмотра
Научные советы
- Физико-математические науки
- Нанотехнологии
- Энергетика
- Материаловедение, механика, прочность
- Информатика, управление, телекоммуникации
- Экология и природные ресурсы
- ER55
- “ESTRUSEEL” ER80
- Научно-образовательный проект "Наука-школе"
- Экология в современном мире
- Генетическая токсикология. Что это такое?
- Геоэкология как новое междисциплинарное направление на стыке географии и экологии
- Адаптивные реакции организма в меняющейся среде
- Биологическое разнообразие и проблемы его сохранения
- О том, как влияют ГМО на видовое разнообразие
- Птицы ООПТ Финского залива
- Охрана природы как культурной ценности
- ЭКОЛОГИЧЕСКОЕ ОБРАЗОВАНИЕ
- Хопёрский заповедник
- Изучение микобиоты Центрально-Лесного государственного природного биосферного заповедника (Тверская область)
- Мохообразные трех особо охраняемых природных территорий Петродворцового района г.Санкт-Петербурга
- Новости
- Конференции
- Малоизученные проблемы
- TOPCONS
- Издания и аналитические работы
- Анализ выполнения раздела «Экология» стратегического плана Санкт-Петербурга
- Научная экологическая конференция школьников и студентов
- Некоторые аспекты экологических проблем: причины и следствия
- О возможности рационального использования воды,очищенной на станциях аэрации Санкт-Петербурга
- О роли научных конференций в становлении молодых ученых
- Роль гидросферы в процессах естественной самоочистки объектов природной среды
- Экологическая безопасность Северо-Западного региона
- Историческая справка
- Острые проблемы
- М.Г. Огурцов, «Современное потепление в контексте палеоданных о глобальной температуре Земли за последние 1000 лет»
- Рациональное использование природных ресурсов восточной части Финского залива
- С.В. Авакян, «Солнечно-земные связи, погода и современное изменение климата»
- С.В. Авакян, «Сравнение энергетики антропогенных и природных источников современного глобального потепления»
- С.В. Авакян, «Перспективы работы комиссии по физическим проблемам изменения климата»
- Статья А.В. Мещерской
- Отчет о деятельности
- За 2003 год
- Решения и постановления
- Постановление по вопросу «Молекулярная генетика как фактор экологизации земледелия»
- Постановление по вопросу «О перспективах охраны Ладожского озера»
- Постановление по вопросу «Оценка техногенного воздействия на планету Земля в реальном масштабе времени»
- Рекомендации семинара «Индикаторы устойчивого развития для Санкт-Петербурга»
- Рекомендации конференции «Основные направления деятельности Администрации Петербурга по вопросам охраны окружающей среды..»
- Решение семинара «Проблемы охраны водной системы Ладога-Нева-Финский залив от биологического загрязнения»
- Решения и постановления
- За 2005 год
- За последние годы
- За 2003 год
- Председатель и бюро Совета
- Проект «Наука — школе», часть 1
- Разработки научно-исследовательских институтов
- Структура совета
- Функциональные связи и деятельность Совета
- Экспертный опрос
- Биология и медицина
- Бюро совета и состав научного совета
- Историческая справка
- Основные направления деятельности
- Семинары и конференции
- Специализированные научные советы
- Научный совет «Приборы для медико-биологических исследований»
- Научный совет по проблемам генетики и биотехнологии
- Научный совет по проблемам молекулярной и клеточной биологии
- Научный совет по проблемам общей биологии
- Научный совет по проблемам физиологии
- Научный совет по фундаментальным проблемам клинической медицины
- Междисциплинарные проблемы транспортных систем
- Развитие агропромышленного комплекса
- Общественные и гуманитарные науки
- Химические науки
- Науки о Земле


